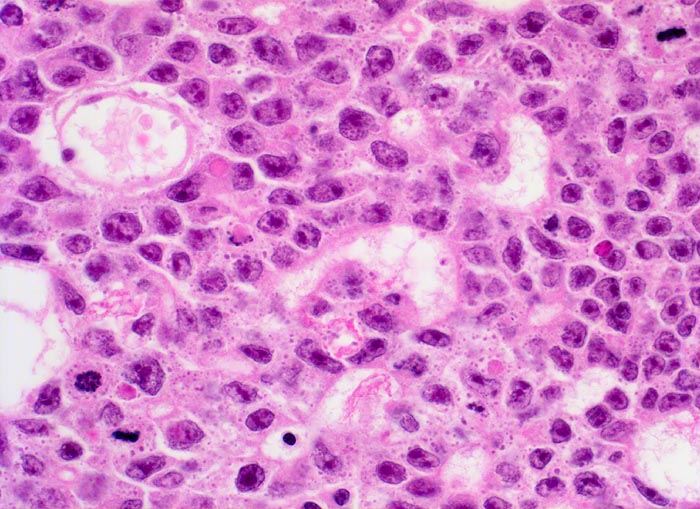

PathoPic – image database / PathoPic ID 4685 - Embryonales Karzinom des Hodens
de
Diagnose
Embryonales Karzinom des Hodens
Diagnose Gruppe
maligner Tumor
Topographie
Hoden
Topographie Gruppe
Genitalorgane, männlich
Beschreibung
Zusatzbefund
Makroskopisch aus mehreren unscharf begrenzten, bunten, teils hämorrhagischen Knoten bestehender Tumor von 3cm Durchmesser.
Klinik
Schmerzlose Hodenvergrösserung.
Bilder Typ
Histologie
Vergrösserung
400
Alter
34
Geschlecht
männlich
Datum
Ersteintrag: 06.05.2002
Update: 04.02.2024